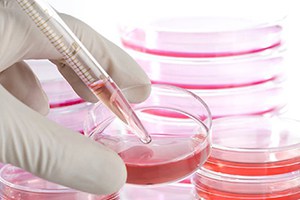

Bone Marrow Transplant Procedure
Price :- From $ 35000

Bone marrow is a soft, fatty tissue inside your breast, skull, hip, rib and spine bones and contains stem cells. Stem cells produce red and white blood cells and platelets, which enable your blood to clot.
A bone marrow transplant procedure becomes necessary as the only treatment option for some patients with forms of leukemia, severe anemia from destruction of bone marrow or malfunction and various immune deficiency diseases.
The following table shows the estimated U.S. average billed charges per transplant in 2008, as revealed in the Milliman Research Report of April, 2008:
| Transplant | Allogeneic | Autologous |
| 30 Days Pre-Transplant | $30,400 | $31,300 |
| Procurement | $29,400 | $21,200 |
| Hospital Transplant Admission | $380,700 | $169,900 |
| Physician during Transplant | $19,600 | $10,600 |
| 180 Days Post-Transplant Admission | $197,100 | $62,100 |
| OP Immuno-Suppressants and other Medications | $19,600 | $5,300 |
| TOTALS | $676,800 | $300,400 |
The cost of bone marrow transplant may be impossible for some patients to manage, especially for those without insurance coverage.
Yet the cost of a bone marrow transplant through HealthCare Travel Council Of India is substantially less than other routes, and this life-saving procedure can be within financial reach.
Bone marrow transplant procedure
A bone marrow transplant is not a surgical procedure; rather, it is much like receiving a blood transfusion.
Your diseased or malfunctioning bone marrow is destroyed by chemotherapy or radiation prior to receiving healthy stem cells through an infusion by a catheter.
The infusion will take several hours.
The goal of a bone marrow transplant procedure is for the new stem cells to travel to your bone cavities, form new bone marrow and produce normal blood cells.
There are three different sources of bone narrow for transplants:
- Autologous:
Stem cells are withdrawn from you before chemotherapy and radiation.
After your bone marrow has been destroyed, your stem cells are returned.
You are, in essence, your own donor. - Allogeneic:
Stem cells are supplied by a donor.
Blood tests are conducted to ascertain the donor is a good genetic match with your bone narrow to prevent your body from rejecting the donor’s stem cells. - Umbilical:
Stem cells are extracted from the umbilical cord of a baby at birth and various tests performed before they are frozen until needed.
Bone marrow transplants carry risks, as do all medical procedures.
The level of risk is dependent on your medical condition, age, health, pre-bone marrow transplant treatments and type of bone marrow transplant you have.
It is strongly recommended you speak with your medical specialists to ensure you fully understand the risks involved.
You can expect your hospitalization period to be up to eight weeks.
Bone marrow preparation
You will undergo a series of tests to determine if you are healthy enough to receive a transplant.
Your major organs will examined for any impairment.
These tests are done on an outpatient basis.
A bone marrow transplant is an enormous physical and psychological strain.
Preparation is very important for a bone marrow transplant recipient.
Several days before your transplant, a catheter will be placed into a large vein just above your heart for administration of medications and blood test samples.
You will be given strong dosages of chemotherapy or radiation, or both, to destroy your bone marrow.
One or two days after you have finished the chemotherapy regime, you will receive your bone marrow transplant.
Bone marrow recovery
You will be easily disposed to infection and bleeding as you wait for your new stem cells to begin producing normal blood cells.
There will be strict protocol for medical staff and visitors to prevent infections and restrictions on what items are permitted in your room.
You will likely receive large amount of antibiotics and blood transfusions during the first 2 to 4 weeks after the transplant.
Once blood tests show that your bone marrow is generating normal blood cells, you will be weaned off the antibiotics and no longer require blood transfusions.
Your recovery period will be extended.
After discharge from the hospital, another 2 to 4 months are expected until a full recovery.
During this time, you will need to be monitored closely and your activities will be limited to avoid infection.
Although a bone marrow transplant procedure is an arduous experience, many patients have an enhanced quality of life afterwards.
Stem Cell Therapy Options
Price :- From $ After Evaluation

WideState Mediacre is the leader in Stem Cell Therapy options which are targeted to treat various medical conditions. Stem Cell Treatment, not yet available in the United States, can be easily scheduled by contacting our staff using our online form.
Diseases treated with Stem Cell therapy include:
- Stem Cell Therapy for Diabetes: type I, type II, Juvenile Diabetes
- Stem Cell Therapy for Congestive Heart Failure
- Stem Cell Therapy for COPD and lung disorders
- Stem Cell Therapy for Multiple Sclerosis
- Stem Cell Therapy for Stroke
- Stem Cell Therapy for Parkinson’s Disease
- Stem Cell Therapy for Alzheimer’s Disease
Diseases treated with Stem Cell therapy include:
- Stem cells have the potential to self-renew, replacing diseased or damaged tissues
- Minimal risk of rejection, as the stem cells are taken from the patient’s own body
- Minimal side effects when compared to other forms of treatment
- Formerly untreatable diseases can be treated through stem cell transplantation procedures
Many other conditions are treatable with the patient’s own stem cells. Your procedure, including travel to and from the destination hospital, is managed by registered nurses from beginning to conclusion, guaranteeing you the optimum experience. We have subjected our stem cell doctors to an extensive review process in order to boost your potential for success.
Most importantly, we provide you with a personal touch from start to finish. What is Stem Cell Therapy?
Stem cell therapy is a type of treatment in which a person’s own cells are removed, cleaned, separated, and introduced into damaged tissue in order to treat disease or injury. Stem cells are removed from the patient’s hip or iliac bone and then sent to the lab for cleaning and separation.
Will I have to be treated more than once?
Currently,Adult Stem Cell research has demonstrated the continual healing and regenerating power of individual’s stem cells. Patients around the world have received more than one treatment as well as treatments to more than one body area. The need for additional treatments is very individualized, and stemcell research is constantly being refined.
What effects can I expect after treatment?
Although success cannot be guaranteed, many patients have found relief from symptoms after stem cell treatment for heart and lung conditions as well as types of Diabetes and neurodegenerative disorders.
Stem Cell Therapy and Religion
Currently, there are no religious or ethical issues with adult stem cell therapy. These stem cells are derived from adults and not embryos, and, therefore, pose no moral issues. In the future, other sources of stem cells may include umbilical cord cells as well as placental cells, which also do not create any religious concerns. WideState Mediacre does not participate in embryonic stem cell therapy nor research due to the potential for abuse. As an organization, we choose to stay away from controversial matters so that we can focus on improving our patient’s health and wellness.
WideState Mediacre also provides information on stem cell research, treatment success, and transplant procedures. Such information can help to inform you of the basics of stem cell therapy. We also provide more specific information on the exciting new developments in stem cell research, such as advancements with specific types of adult stem cells, bone marrow stem cells, and stem cell therapy for cancer and diabetes treatment.
With the current expansion of stem cell research and development, you can expect quality coverage in such countries . You may fill out out our online form for a free consultation to get you started. HealthCare Travel Council Of India provides you with staff assistance before, during, and after your treatment, to ensure that you receive the most detailed attention throughout the process.
Disc Fusion Options
Price :- From $ 7500

Disc fusion through HealthCare Travel Council Of India is affordable through our partnerships with state of the art hospitals in the india . Medically trained case managers provide patient advocacy to ensure you receive the best medical care available for your procedure. Hospitals, officially recognized accreditation agencies such as JCAHO and the Joint Commission International (JCI), are thoroughly investigated prior to selection. Your procedure, including travel to and from the destination hospital, is managed by registered nurses from beginning to conclusion, guaranteeing you the optimum experience.
Most importantly, we provide you with a personal touch from start until well after your return home.
What is disc fusion?
A disk fusion is a surgery performed to link together individual segments, or vertebrae, within the spine. The spinal column, or backbone, is made up of individual bones called vertebrae. These bones are stacked together. Between each of the vertebrae is a soft cushion called a disc. The disc spaces allow each vertebrae to bend slightly; this motion allows us to bend forward and arch backwards. A spine fusion is a surgery that is done to link together two or more vertebrae. When there is a problem with the vertebrae (often a problem with the disc space), your doctor may recommend a spine fusion to eliminate the motion that occurs within that portion of the spine. By linking together the vertebrae, your doctor is trying to eliminate the source of your back problem. Spinal fusion may be recommended for
- Abnormal curvature of the spine (scoliosis or kyphosis)
- Injury to the spinal vertebrae
- Protrusion of the cushioning disc between vertebrae (slipped disc, herniated nucleus pulposus)
- Weak or unstable spine caused by infections or tumors
Spine Surgery Options
Price :- From $ After Evaluation

Spine surgery is the surgical procedure which is useful to correct deformities and to relieve various painful symptoms from the back.
There are various medical disorders and trauma injuries to the spinal column that can be successfully treated using one of the many effective spinal surgery techniques.
What are the types of Spine surgery?
The various types of spinal surgery are categorized mainly according to the approach the surgeon takes to perform the surgical procedure.
These are the 3 main approaches utilized when performing a spinal surgery:
- Anterior approach – In this, the surgeon will make an incision in the front of the body (usually in the chest or abdomen) to access the damaged portion of spine.
- Posterior approach – In this, the surgeon will make an incision in the back directly over the damaged portion of the spinal column.
- Lateral approach – In this, the surgeon will make an incision at the side to access the damaged part of the spinal column.
These approaches are used in conventional and minimally invasive surgery as well.
What are the various Spine Surgery treatments?
As there are various causes that can result in intense back and neck pain, the type and approach for spine surgery treatment also varies accordingly.
These are some of the most common spine surgery treatments performed all over the world today:
Anterior Lumbar Inter-body Fusion (ALIF)
In this spinal surgery, the surgeon will use an anterior approach (incision in the abdomen) to reach the damaged spinal portion. This helps the surgeon to easily remove the damaged inter-vertebral disc. When the damaged disc is removed the empty space is filled with a bone graft or an artificial spacer device to help fuse the two consecutive vertebrae.
Anterior Cervical Discectomy – In this form of spinal surgery, the surgeon will use conventional open-type of surgical method to get a lateral approach. This requires the surgeon to make an incision at the side of the neck and access the damaged portion of the cervical spinal column. This allows the surgeon to remove the damaged inter-vertebral disc with efficiency and place a bone graft or an artificial spacer device to support in fusing the two consecutive vertebrae together.
Bone Grafting – In this spinal surgery type, the surgeon places a bone graft into an area of the spinal column that requires support with fusion. The bone graft may be autologous (from the patient’s body) or allograft (from a donor) or an artificial device (spacer).
Discectomy – In this spinal surgery, the surgeon will remove a damaged inter-vertebral disc or a part of it. This is most useful in case of herniated inter-vertebral discs which then cause painful and restrictive symptoms.
A discectomy is also used to restrict the motion of two consecutive vertebrae. This is the spinal fusion technique useful in treating pain being caused from the movement of damaged vertebrae. This surgery can be performed in all areas of the spinal column (cervical, thoracic and lumbar) and with different surgical approaches too.
Endoscopy – This is a minimally invasive spinal surgery method. It uses an endoscope, a thin and flexible surgical tube fitted with light-source, video camera and miniature surgical instruments, to perform the required surgical procedure.
An endoscopic spinal surgery is useful in successfully treating scoliosis, kyphosis, etc.
Foraminotomy/Foraminectomy – These are two sides of the same spinal surgery method. The foramen is the natural groove inside all vertebrae which together form the spinal canal. This spinal canal contains the sensitive nerve roots and spinal cord, stretching from the base of the skull to the lower back. Undue pressure on this canal causes the nerve roots and spinal cord to become compressed. This results in painful and motion-restrictive conditions that affect everyday life intensively.
In a foraminotomy, the surgeon will remove bones and soft tissues that are pressing against the spinal cord. This helps to decompress the spine and give relief from painful symptoms. A foraminectomy differs in the sense that the surgeon will remove comparatively larger portions of bone and soft tissues from the spinal canal.
Laminectomy – In this spinal surgery, the surgeon will remove a portion of the lamina of the vertebrae which is causing the spinal cord and nerve roots to get compressed. The lamina may be completely or partially removed to make sufficient space for the spinal cord.
Microdiscectomy – This is a minimally invasive spinal surgery technique. It is most useful to remove bone debris from the spinal column safely. As it uses least invasive technique the patient is able to have less pain after the surgery and also recover faster.
Spinal fusion – The spinal fusion surgery is aimed at creating a single mass out of two consecutive vertebrae by fusing (welding) them together. In case the movement of the vertebrae is causing pain to the patient, the surgeon will use a bone graft or surgical adhesive and artificial support devices to fuse the vertebrae together.
Why choose HealthCare Travel Council Of India for Spine Surgery?
HealthCare Travel Council Of India is synonymous with providing the best-in-class medical tourism assistance all over the world. WideState Medicare ensures high-quality spinal surgery treatment at the best and most renowned hospitals at popular international destinations, including US, UK, Thailand, Malaysia, Dubai to name a few. WideState is committed to providing complete travelling and treatment care to patients with affordable bespoke treatment packages.
Hip Replacement Surgery
Price :- From $ 6500

Total Hip Replacement procedures through HealthCare Travel Council Of India are high quality, affordable and convenient. You receive the benefit of our expertise and the compassion of our registered nurses. We are affiliated with hospitals that are approved by JCAHO or the Joint Commission International (JCI) . Our case managers are registered nurses who consult with you to make certain all your concerns and questions are taken care of to your satisfaction.
What is Hip Replacement Surgery?
The purpose of total hip surgery is to remove the two damaged and worn parts of the hip joint – the hip socket, acetabulum, and the ball, femoral head – and replace them with smooth, artificial implants called prostheses, which will help make the hip strong, stable and flexible again. The hip implant is comprised of four parts that work together to restore the original function of your ball-and-socket joint
- A metal hip stem that is inserted into the top of your thighbone
- A metal cup which holds the cup liner
- A cup liner which holds the femoral head
- The femoral head or ball which is attached to the hip stem and inserted into the liner to form the ball-and-socket joint
Hip Resurfacing
Price :- From $ 4500

Hip Resurfacing Options through HealthCare Travel Council Of India are high quality, affordable and convenient. You receive the benefit of our expertise and the compassion of our registered nurses as you receive care in the US or outside the US. We are affiliated with hospitals that are approved by JCAHO or the Joint Commission International (JCI) and associated with respected US medical institutions, including Johns Hopkins and Harvard Medical. Our case managers are registered nurses who consult with you to make certain all your concerns and questions are taken care of to your satisfaction.
What is Hip Resurfacing Surgery?
The procedure is very bone conserving as the head of the femur is retained. Instead of removing the head completely, it is shaped to accept an anatomically sized metal sphere. There is no large stem to go down the central part of the femur and the surface of the acetabulum (the socket) is also replaced with a metal implant, which is press fit directly into the bone.
The resurfacing components are made of ‘As Cast’ cobalt chrome which is finely machined to produce a very high quality surface with a low friction finish, hence low wear. The BIRMINGHAM HIP RESURFACING has the largest independently verified clinical history of any resurfacing device available today. Please look at the following video
Disc Replacement
Price :- From $ 6000

Disc replacement at low cost and high quality is now within reach through HealthCare Travel Council Of India. Our nurses arrange all aspects of your treatment and will act as your patient advocate. We have partnerships with some of the best hospitals in the INDIA .
What is Total Disc Replacement?
Total disc replacement is an alternative to spinal fusion for some patients.
During disk replacement surgery, the surgeon will remove the damaged disc and replace it with an artificial disc. The goal of this and most all spine surgeries is to help to reduce your pain and restore activity.
The goal of any artificial disc is to:
- Maintain motion in the area of the spine where the disc is implanted
- Maintain motion in the area of the spine where the disc is implanted
- Maintain stability in your spine Restore proper disc height between the vertebrae above and below the disc
- Re-establish proper spinal alignment / curvature of your spine in the lumbar area
- Reduce discogenic pain, especially lower back pain
Suitability for Total Disk Replacement
Disk replacement is an alternative to spinal fusion for some patients. Your eligibility for disc replacement can only be determined by your doctor. Before you and your doctor agree to surgery as an option, your doctor will want to make sure that you’ve given nonsurgical treatments a reasonable trial. Also, your doctor needs to receive all pertinent medical records such as Xrays, MRIs and in some cases a study called a discogram, which is a special X-ray examination that involves the use of a dye. The dye, injected into a disc, serves to make it appear better on an X-ray. The injection of dye also may produce a pain similar to your ongoing back pain, which helps your doctor pinpoint that disc as the source of your pain. HealthCare Travel Council Of India will arrange for all your records to be transmitted to your assigned doctor.
Total Disk Replacement Surgery
When undergoing total disc replacement surgery, you will be lying on your back and the surgeon will operate on your spine through an incision near your belly button. The surgeon will remove the diseased disc and replace it with an artificial disc. There are alternative treatments to this surgery. You should discuss these other possibilities with your surgeon before you make your decision.
Total Disk Replacement Recovery
In most cases, immediately after surgery, your heart and lung function will continue to be monitored, and your doctor will prescribe medicines to control pain and nausea. The average hospital stay for disc replacement surgery at our partner hospitals is about ten days, which typically is much longer than what you would receive in the INDIA with the advantage of medically trained people always being close by. Before hospital discharge your doctor will discuss a program to gradually increase your activity. It is possible that you will be asked to wear a back brace or elastic bandage to support your abdominal muscles after surgery.
Life After Disk Replacement
Pain relief, the reduction of further degeneration and resumption of daily activities are typical goals of spine surgery. While both fusion surgery and artificial disc replacement can provide pain relief and stability, with spinal fusion the vertebrae surrounding the disc space are immobilized, and therefore limit flexibility in that area of the spine. Laboratory testing shows that patients who have undergone total disc replacement have more movement in the spine. Nobody can guarantee that after disc replacement surgery you will never feel pain again or that your spine will fully regain its flexibility. If you’re like the majority of spinal surgery patients, you’ll experience a decrease in pain and you’ll gradually be able to increase your level of activity. With your pain minimized or no longer an issue, your concentration level on task will be noticeably better.
What is Pediatric Orthopedic surgery?
Price :- From $ After Evaluation

Orthopedic surgery is used to treat a variety of medical disorders, diseases, conditions, trauma and injury that affect the musculoskeletal system in a person.
These involve treatment of injuries such as sports injuries to the muscles, tendons or bones and tumors, infections, degenerative diseases and birth defects that affect any part of the musculoskeletal structure.
What are the common medical conditions treated with Orthopedic surgery?
Orthopedic surgery covers surgical treatment of various medical disorders and injuries to the skeletal structure as well as the muscles and tendons in the body.
Although the number of diseases and disorders treated with orthopedic surgery is large, these are some of the most common conditions that are treated using this type of surgical treatment:
Joint pain
Joint pain is most commonly felt as we age. It is also caused due to various medical disorders as well as injuries. Joint pain can be felt in any joint of the body, including the knee, elbow and knuckles, etc.
Back/Neck pain
Back and neck pain are caused due to various reasons, from mild injuries and pulled muscle to neurological disorders also. There are various orthopedic treatments available to treat back and neck pain effectively. Your doctor (or orthopedic specialist) will determine the exact orthopedic treatment which is suitable for your particular case.
Arthritis
Arthritis is one of the most common medical disorders that cause painful and inflamed joints. This disease causes the various joints in the body, mainly the knee joint, to become swollen, tender and painful to move.
There are various orthopedic treatments for arthritis however the most suitable orthopedic surgery or treatment will be advised to you after reviewing various factors in your particular case.
Ligament/Tendon injuries
The tendons and ligaments in the body provide the main connection between the muscles and bones in all part of the body. These are very important for supporting and allowing the muscles to move the bones (and limbs)
Fractures
Fractures are breaks or fissures that develop in bones after an injury or also due to several medical disorders. Mild fractures are treated with surgical resetting of the broken bones, while compound fractures require extensive orthopedic surgery to put the multiple bone pieces back in natural position and provide artificial support till it heals naturally.
What are the various Orthopedic surgery and treatment methods?
There are a large number of orthopedic treatment and surgery techniques. The exact orthopedic treatment and technique used in every case depend mainly on certain factors, such as the type of medical disorder or injury causing the condition as well as the patient’s age and overall health among others.
These are some of the most common orthopedic surgery and treatment methods used today:
For Bones:
Orthopedic surgery for medical diseases, disorders and injuries to the bones include –
- Bone grafting – This modern orthopedic surgery involves removing a small portion of biological tissue (such as cartilage, bone marrow, skin biopsy, etc) from another part of the body to repair the damage caused on a bone. At times, the orthopedic surgeon will also use artificial bone materials to substitute for natural bone grafts.
Laminectomy – In case the spinal cord (or nerve roots) feels abnormal pressure in the spinal canal due to constriction of the space, the orthopedic surgeon might perform a Laminectomy. This requires the orthopedic surgeon to remove a small portion of the damaged vertebra (lamina) from the back. This helps to relieve the pressure from the nerve roots or spinal cord and treats the symptoms successfully.
For Joints:
Orthopedic surgery for treating medical conditions and injuries affecting the joints in the body are –
- Arthroscopy – Also called as arthroscopic orthopedic surgery, it is an efficient minimally invasive surgical technique that can help to assess the damage to the joint using a small camera attached to the arthroscope (small flexible optical fiber tube) which is inserted through a keyhole (very small) incision. This device is also used to remove the damaged bones or tissue from various joints, such as knee, elbow, wrist, etc.
- Arthroplasty/Joint Replacement surgery – Joint replacement surgery is the most effective and common orthopedic surgeries. This involves replacing a damaged joint in the body (such as knee, hip, etc) with an artificial joint implant. This is mostly a last resort in case other orthopedic surgical and non-surgical treatments are unsuccessful.
For Muscles, Tendons, Fascia and Bursa:
These are the various orthopedic treatments and surgeries for different types of medical disorders and injuries that affect the muscles, tendons, fascia and bursa –
- Fasciotomy – This orthopedic surgical treatment is used to relieve pressure being caused by a soft connective tissue. This is most useful in saving limbs that are at risk of tissue atrophy due to nerve damage or muscle death.
- Open Release – As the name suggests, this orthopedic treatment is useful to treat conditions where ligaments are putting abnormal pressure on surrounding bone or other tissue/organ. As the orthopedic surgeon cuts the abnormally tightened ligaments the pressure is relieved and saves the risk of nerve damage, etc.
Why choose HealthCare Travel Council Of India for Orthopedic Surgery?
HealthCare Travel Council Of India has been known to provide the best and most efficient services for orthopedic surgeries and treatments all across the world. HealthCare Travel Council Of India is connected to a vast web of high-class orthopedic specialty hospitals at various international destinations, including India, Turkey, Malaysia, Thailand, etc for efficient travel to get orthopedic treatment.
HealthCare Travel Council Of India helps patients at each step of the way to get world-class orthopedic treatment at affordable cost.
What is Cancer Radiation Treatment?
Price :- From $ 3000

Radiation therapy treatment is a form of therapy for treating cancer treatment that uses x-rays as a means of damaging the DNA of malignant tumor cells. It is also known as “radiotherapy and “radiation oncology”.
Most common types of cancer respond positively to radiation therapy. It is used for many different types of cancers. Radiation therapy will damage normal cells in the process of eradicated cancer cells.
However, most normal cells will recover quickly from the treatment. The main goal of radiotherapy is damage as many cancer cells as possible while minimizing damage to normal cells.
Please refer to the following pages for more information about specific cancer radiation treatments:
- Brain Cancer Radiation Treatment
- Liver Cancer Radiation Treatment
- Lung Cancer Radiation Treatment
- Pancreas Cancer Radiation Treatment
- Spine Cancer Radiation Treatment
Radiation therapy may be used prior to surgery in order to shrink tumors. It can also be used after surgeries to prevent a relapse of cancer cells. Radiation therapy has many applications and may be used either separately or in combination with other types of therapy such as hormone therapy or chemotherapy. For some types of tumors it may be the only type of treatment needed.
How does the Cancer Radiation Treatment Work?
Radiation therapy is generally applied directly to a tumor. For this reason it is considered to be a “localize” therapy. This means that it treats only a specific portion of the body. This is different from “systemic” types of therapies that travel throughout the entire body (such as chemotherapy).
During the procedure, the high energy rays are aimed at the tumor from several different angles. This serves the purpose of avoiding damage to normal cells, while providing a larger dose to the actual tumor. It also helps in allowing the rays to pass through the various layers of tissue and organs without damaging them.
Sometimes the radiation field may encompass small portions of normal tissue or other systems that are involved such as surrounding lymph nodes.
This is because the position of the tumor can sometimes be altered by many factors.
It is important that the entire malignant growth be treated with the rays. These forms of cancer radiation treatment are usually administered once or twice daily
What are the side effects of Cancer Radiation Treatment?
Since radiation therapy inevitably results in damage to healthy cells along with the malignant growths, it can have undesirable side effects.
Depending on the location of the tumor, these may include: alopecia (hair loss), digestive problems, diarrhea, lung damage, urinary problems, changes in sexual function, and other radiation-associated effects.
Recovery time is usually swift, as external beam radiation is usually an outpatient procedure.
Other forms of radiotherapy such as internal radiation therapy may require a few days of hospitalization after the procedure is completed. Side effects can last anywhere from weeks to months. This is considered to be much shorter than other forms of treatment such as chemotherapy.
What is Ovarian Cancer?
Price :- From $ 4000

Ovarian cancer is the abnormal growth of tissue cells covering the ovaries. Ovarian cancer originates in the ovaries and can then spread to surrounding parts swiftly. This is one of the more prevalent types of cancer in women and is mostly seen developing in post-menopausal women.
Ovarian cancer can affect cell growth in one or both the ovaries. The ovaries are two small glands on both sides of the uterus. Ovaries produce the female sex hormones, store and release the eggs (ova).
Ovarian cancer can be effectively treated if detected at an early stage.
What are the symptoms of Ovarian Cancer?
In certain cases, ovarian cancer displays early signs, such as:
- Pelvic/abdominal pain
- Frequent bloating
- Eating problems
- Urinary problems – Frequent/urgent urination
The other common symptoms seen for ovarian cancer include:
- Regular indigestion
- Constant fatigue
- Chronic back ache
- Painful intercourse
- Abnormal changes in menstrual cycle
- Frequent constipation
How is Ovarian Cancer diagnosed?
These are the common diagnostic tests and examinations that are helpful in detection, diagnosing and staging of ovarian cancer:
Physical Examination
This includes a pelvic examination and a Pap test. The physical pelvic examination is helpful in finding any abnormal growths (lumps) in the ovaries. The doctor may also advise a recto-vaginal exam to check the internal pelvic organs for cancerous growths.
Biopsy
The doctor will remove a small piece of the suspected ovary through minimally invasive surgical method (laparotomy).The removed sample of the ovary tissue is sent to a pathological laboratory for a detailed analysis.
CA-125
The Cancer Antigen 125 (CA-125) level test is helpful to check for a certain protein which is found over the cancerous ovarian cells.
Pelvic/Trans-vaginal Ultrasound
This ultrasound imaging technique is used to check for abnormal lumps in the ovary.
Imaging diagnostic tests
Other imaging diagnostic tests, such as MRI (Magnetic Resonance Imaging) test and CT (Computerized Tomography) scan are useful for detailed imaging of the internal pelvic region and check for signs of abnormal ovarian growths.
How is Ovarian Cancer treated?
There are several types of treatments for ovarian cancer. The doctor will decide on the most effective ovarian cancer treatment for the individual case depending on various factors, such as age, health status, stage and type of ovarian cancer.
These are the most common ovarian cancer treatment methods that are effective in treating the cancer of the ovaries and also help in preventing it from recurring later on in life:
Chemotherapy
Chemotherapy is the medicinal treatment for ovarian cancer. Chemotherapy is useful in reducing the size of the tumor in the ovaries. This treatment also slows down growth rate of the cancerous cells.
Chemotherapy is mostly advised after a surgical treatment, where the surgeon is not able to remove the cancerous tissue completely using surgical methods alone. Chemotherapy helps to target the blood source of the cancerous cell and shrink its size significantly. This treatment is also advised before a surgical treatment for ovarian cancer to shrink a large-sized ovarian tumor so that it can be safely removed afterwards using surgical methods.
Chemotherapy medications can be administered using:
- Oral method (through the mouth)
- IV (Intravenous) method (through a tube connected to a vein)
- IP (Intra-peritoneal) method (through a thin tube inserted in the body)
Surgical
Surgical treatment is considered to be the main treatment method for ovarian cancer.
There are several surgical procedures that are performed (individually/combined) that are helpful in treating ovarian cancer effectively, such as:
- Total Hysterectomy – This surgical procedure is used to remove the cancer-affected cervix and the uterus.
- Unilateral Salpingo-Oopherectomy – This surgical procedure is used to remove one ovary and fallopian tube that have been affected.
- Bilateral Salpingo-Oopherectomy – This surgical procedure is used to remove both the ovaries and fallopian tubes.
- Omentectomy – This surgical treatment is used to remove the omentum (fatty tissue attached to abdominal organs) when the cancer spreads to other abdominal organs.
Radiotherapy
Radiation therapy for treating ovarian cancer involves targeting the cancerous ovarian cells with high-energy radiation. These particle waves are able to disrupt the cancer growth fast and destroy the cancerous cells within the ovaries.
Why choose HealthCare Travel Council Of India for treatment of Ovarian Cancer?
HealthCare Travel Council Of India is the prime provider of world-class medical tourism all over the globe. HEALTHCARE TRAVEL COUNCIL OF INDIA has association with a wide network of high-standard hospitals and healthcare facilities across the globe that specializes in women’s health and cancer. HEALTHCARE TRAVEL COUNCIL OF INDIA provides all-round assistance for patients to travel abroad to various international destinations, such as Thailand, India, Malaysia, US, UK, etc for effective ovarian cancer treatment at affordable cost.
What is Cervical Cancer?
Price :- From $ 500000

Cervical cancer causes abnormal development in the tissue cells of the cervix. Prompt detection and fast treatment is vital to successfully treat this cancer and prevent additional serous health complications from arising.
What causes Cervical Cancer?
Cervical cancer develops due to the action of the HPV (human papillomavirus). This virus is contacted as an STD (sexually transmitted disease) through unsafe sexual intercourse with an infected person.
Although there are various types of HPV, not all of them result in cervical cancer. Mostly adults are affected with this virus and at times the infection is mild enough to go away on their own. However it is liable to result in serious genital warts that can develop into cervical cancer.
What are the symptoms of Cervical Cancer?
The abnormal changes occurring in the cervical cells when result in development of cervical cancer it causes various symptoms, such as:
- Abnormal vaginal bleeding
- Painful sexual intercourse
- Abnormal vaginal discharge
- Abnormal changes in menstrual cycle
- Anemia (from abnormal vaginal bleeding)
- Constant leg, back or pelvic pain
- Urinary disorders caused by blockage of kidney or ureter
- Leakage of urine/stool into vagina
- Unexplained weight loss
How is Cervical Cancer diagnosed?
There are several diagnostic exams and tests that help detect cervical cancer. An early detection method is used to identify potential cervical cancer, with:
Pap test – This is an early detection technique for cervical cancer. This test is useful in finding abnormal changes in cervical cells, which helps to determine the risk of cervical cancer.
The doctor will take into consideration your age, overall health, weight, etc to schedule the Pap test.
When the doctor suspects cervical cancer, these are the various diagnostic tests that help to confirm the diagnosis:
Cervical Biopsy (Colposcopy) – This test is useful to find if cancer cells have affected the surface of the cervix and the spread of the cancerous cells in it.
Endo-cervical Biopsy (Curettage) – This diagnostic test help to determine if the cancer cells have affected the cervical canal passage.
Cone Biopsy (LEEP – Loop Electrosurgical Excision Procedure) – These series of advanced diagnostic tests help to remove affected cervical tissue for detailed pathological analysis.
The doctor will also recommend several diagnostic tests that help to determine the stage (level of severity) of the cervical cancer, which helps to select the best-suited cervical cancer treatment.
These are the staging tests for cervical cancer:
Chest X-ray Test – This test helps to check lungs for cancer signs.
CT (Computerized Tomography) Scan – A CT Scan helps to use advanced x-ray imaging technique for better viewing of the various organs inside the body for signs of advanced cervical cancer.
Ultrasound Test – This test uses reflecting sound waves to determine abnormalities in the internal organs and soft tissue.
MRI (Magnetic Resonance Imaging) Test – This is a high-tech imaging technique that uses powerful electromagnetic waves to see inside the body with non-invasive diagnostic technique.
How is Cervical Cancer treated?
Cervical cancer detected in the early developmental stages can be successfully treated. There are several factors (such as your age, health status, etc) that will help the doctor determine the best-suited cervical cancer treatment for you.
These are the most common cervical cancer treatment methods:
Chemotherapy
This is the medicinal treatment technique for early-stage and mild form of cervical cancer. This technique uses specially-designed medicinal drugs to combat the abnormally growing cervical cells.
Chemotherapy aims to reduce the size of the cervical tumor by cutting off its blood supply mainly.
Radiotherapy
Radiation therapy is useful for treating specific stages of cervical cancer. This treatment technique is also often used in combination with surgical treatment methods for added effectiveness.
Radiotherapy uses precisely controlled and accurate dosage of high-energy radiation particles (such as x-rays) to target and destroy the cancerous cells from developing. In case the cervical tumor is considerably larger in size then radiotherapy helps to decrease its size which can then be removed using surgical methods.
Surgery
The doctor will advise surgical treatment of cervical cancer depending on the location and extent of cervical cancer as well as future plans for getting pregnant.
Surgical treatment for cervical cancer may include:
- LEEP – This is an innovative surgical treatment that helps to remove a wedge of the cancer-affected cervical tissue.
- Radical Trachelectomy – This surgical technique is used to remove the cervix along with a portion of the vagina and the pelvic lymph nodes as well. The uterus is not removed in this.
- Hysterectomy – This is an extensive surgical treatment for cervical cancer. It removes the cervix and the uterus as well. The doctor may choose to remove the fallopian tubes and ovaries too to prevent the cancer from returning.
- Bilateral Salpingo-Oopherectomy – This surgical treatment for cervical cancer removes the fallopian tubes and both the ovaries.
- Pelvic Exenteration – This is the most extensive pelvic surgical procedure. This surgical treatment for cervical cancer is advised when the cancer has spread to affect the lower abdomen and the pelvic region. This surgery requires removing the bladder, rectum, lower colon, ovaries, vagina, uterus and cervix. Artificial orifices are made to pass out waste from the body efficiently.
Why choose HealthCare Travel Council Of India for Cervical Cancer treatment?
HealthCare Travel Council Of India is the world’s leading popular medical tourism company. HEALTHCARE TRAVEL COUNCIL OF INDIA connects patients with the most renowned cancer specialists to ensure the best diagnosis and treatment for every cervical cancer patient. HEALTHCARE TRAVEL COUNCIL OF INDIA aims to provide global-class medical tourism services at affordable rates to international patients from all over the world.
What is Cancer Treatment?
Price :- From $ After Evaluation

Cancer treatment is a number of conventional and non-conventional medical treatment methods that are used to treat the large varieties of cancers that develop in a person. Cancer treatment varies according to the type of cancer, it’s location, size, physiology, etc.
What are the different kinds of Cancer?
There are different types of cancers that affect people. The cancers are classified mainly according to the specific part of the body which they affect, as well as the types of cancerous cells that are seen in the abnormal tissue growth (or tumor).
Here are the several kinds of cancers:
Carcinoma – Carcinoma affect the epithelial cells in the body. The epithelial cells make up the tissue covering over organs and blood vessels. Carcinoma mostly affects adults. These may be seen in the form of breast cancer, lung cancer, pancreatic cancer, etc.
Sarcoma – Sarcoma affect the connective tissues in the body. Sarcoma affects bones, cartilage and other soft tissues in the body. These are seen as abnormal growth of the mesenchymal cells surrounding the bone marrow.
Lymphoma/Leukemia – Leukemia and lymphoma are the effects of abnormalities in the blood cells. These are known to affect children and adults alike.
Germ Cell Tumor – Germ cell tumor is a cancer that affects the pluripotent cells. Pluripotent cells are the basic cells that later develop into the various types of other cells in the body. This cancer is mostly seen as testicular cancer or ovarian cancer.
Blastoma – Blastoma affect the developing tissues in the embryo. These result in various other complications after birth of the child and are seen in small children.
What are the types of Cancer?
Cancers are categorized according to the part of the body that they affect initially. Below are some of the more common types of cancers that can be seen today:
Brain cancer – Brain cancers are also sub-categorized into several types. Some of the most common brain cancers are cerebellar astrocytoma, ependymoma, malignant glioma, medulloblastoma, etc.
Breast cancer – Breast cancer affects the soft tissue in the breast of women, mainly. Breast cancer is seen in the form of a small abnormal bump or dimple in the breast. It can also be noticed when the size of the breast changes or if there is fluid leakage or a reddish patch on the breast skin.
Cervical cancer – Cervical cancer develops in the cervical region initially, however, it can easily spread to surrounding area. Cervical cancer is mostly detected through constant pelvic pain, painful sexual intercourse and vaginal bleeding among other signs.
Esophageal cancer – Esophageal cancer is also known as throat cancer. This affects the esophagus (food pipe) which connects the mouth to the stomach. Esophageal cancer is often detected when the patient experienced sudden weight loss, trouble in swallowing, change in voice, dry cough, blood in vomit, etc.
Oral cancer – Oral cancer is also known as mouth cancer. It affects the oral cavity (mouth). Oral cancer is seen developing as a lesion in the mouth and quickly spreads to other surrounding tissues.
What are the different types of Cancer Treatments?
As cancer is caused by varying factors and can affect any part of the body, the treatment for cancer also includes several different treatment methods that are proven to be suitable for treating the particular type of cancer.
These are the common conventional and alternate cancer treatment methods:
Surgery
Surgical treatment of cancer is aimed to remove the cancerous tissue (tumor) completely, whenever possible. The surgeon will also remove a marginal portion of the surrounding healthy tissue around the cancerous cells to prevent the risk of the cancer recurring in the future. Surgical methods are used to diagnose and treat cancers.
Radiotherapy
This innovative cancer treatment method involves using high-energy radiation beams to destroy cancerous cells. Radiation therapy uses ionizing radiation technology to destroy suspected and confirmed cancer cells from almost any part of the body.
Radiations therapy can be administered from outside the body, which is the conventional form. A new and innovative radiation therapy for cancer treatment involves inserting a small radioactive device into the body and focusing radiation on to the cancerous cells from the nearest possible location. This is a more precise and accurate form of radiotherapy as it decreases the risk of damage to surrounding healthy tissue from the radiation beams.
Chemotherapy
Chemotherapy is a medical cancer treatment. Chemotherapy involves using a combination of advanced medicinal drugs that are designed to destroy cancer cells.
Chemotherapy is also useful as a preventive measure to stop the growth (spread) of the cancerous cells to affect surrounding healthy tissue.
Immunotherapy
Immunotherapy requires the oncologist to use a variety of innovative techniques that stimulate the patient’s immune system. This technique enables the natural immune system to get the strength to destroy the cancer cells in the body.
Why choose HealthCare Travel Council Of India for Cancer Treatment?
HealthCare Travel Council Of India is especially known to provide extensive cancer treatment services. HEALTHCARE TRAVEL COUNCIL OF INDIA is connected to the largest global network of world-class cancer specialty hospitals. These reliable and efficient cancer care hospitals are located in popular international destinations, such as India, US, UK, Thailand, Dubai, etc for better convenience to patients travelling abroad for cancer treatment. HEALTHCARE TRAVEL COUNCIL OF INDIA is committed to providing assistance to patients for getting the best, most effective and affordable cancer treatment.
Andrology & Urology – An Overview
Price:- From ₹ After Evaluation

Andrology and Urology and two streams of medicine and surgery that treat the variety of disorders, diseases or damage that the male and female urinary tract may suffer. Andrology and Urology combine to treat medical problems relating to adrenal glands, bladder, kidney, testis, prostate gland, urethra and penis.
What are the various Andrology and Urology disorders?
These are some of the most commonly treated medical disorders and conditions in Andrology and Urology:
Cancer/Benign tumors
Andrology and urology often require treatment of a large variety of tumors that affect any part of the male urinary system. The treatments in this section include medical and surgical treatment for renal cancer, adrenal cancer, ureteral cancer, renal pelvic cancer, bladder cancer, prostate cancer, penile cancer, testicular cancer, etc.
Urolithiasis
Also known as ‘kidney stones’ more commonly, this condition is effectively treated by various medicinal drugs, or in emergency or aggravated conditions, the doctor/physician may advise on a surgical options for its treatment.
Voiding difficulty
These are some of the urinary inconsistency problems that are seen mostly in women. These are mostly known to be caused by neurogenic bladder, interstitial cystitis and an overactive bladder.
Male infertility
There are various conditions relevant to causing male infertility, such as erectile dysfunction a variety of other medical disorders. The treatment options vary according to the type of disorder as well as its severity.
Chronic kidney disease
There are a large range of medical disorders that can develop into serious problems with the renal (kidney) functions. These are mainly treated with advanced medical treatment techniques, such as hemodialysis, peritoneal dialysis and kidney (renal) transplant.
Congenital urological disorders
These are a range of birth-defects that are seen affecting a person’s urinary system. In men, these are mostly seen in the form of undescended testis and ureteropelvic cystitis. There are a variety of surgical options useful for treating these and similar other conditions effectively.
Infections
There are various types of infections that can develop in the male urinary tract, such as prostalitis, cystitis and epididymitis. These often result in painful and constant uncomfortable conditions in the patient. There are medical and surgical treatments for these infections.
What are the various Andrology and Urology treatments?
Today, with the huge progress made in medical and surgical technology, there are various innovative and highly-effective Andrology and Urology treatments available to treat the large numbers of medical diseases, disorders or trauma that affect person’s urinary tract.
Let us look at some of the most advanced Andrology and Urology treatment methods:
Robotic Laparoscopic Radical Prostatectomy
This is a highly-advanced and safer prostatectomy procedure. It requires the surgeon using high-tech robotic surgical system to remove the damaged prostate with minimal surgical invasion in the body.
Laparoscopic Adrenalectomy/Nephrectomy
This is also an advanced minimally invasive surgical method that uses special surgical instruments to remove the adrenal gland or the prostate gland when they are damaged or malfunctioning.
Minimally Invasive Endoscopic Surgery
This is actually an umbrella term used to describe a number of innovative least-invasive surgical techniques that are being increasingly used, not only in Andrology and Urology surgical treatments but also in treating a large number of other medical disorders as well.
Bladder Hydro distention
This is an effective diagnostic technique. Bladder hydro distention requires the surgeon to fill the bladder with a saline water solution. This allows the doctor to check for ‘glomerulations’, which are small points that bleed once injected water solution puts sufficient pressure in the bladder when the patient is suffering from interstitial cystitis.
Brachytherapy
This is an advanced cancer treatment technique. It requires the surgeon to insert a small radioactive source near to the cancer/tumor and then bombard it with radiation from a closer range than an outer conventional radiotherapy treatment of cancer can. This is a comparatively safer radiotherapy method as it prevents the surrounding healthy tissue to be damaged from the radiation being used to destroy the cancerous cells.
Uroflowmetry
This is a minimally invasive diagnostic technique. It requires the doctor to measure the consistency of the flow of urine in a person. This is a common diagnostic test to determine the source of pain felt during urination or for the inconsistencies in urination process.
Renal biopsy
A renal biopsy is basically a minimally invasive surgical diagnostic technique where the surgeon will remove a small portion of the damaged kidney. This removed portion is meant to be sent to a pathological laboratory for better and detailed analysis.
HealthCare Travel Council Of India always aims to provide each patient with the best-in-class Andrology and Urology treatments in India, as well as other major international destinations all over the world. Thousands of patients suffering from a large variety of urological disorders have received effective treatment for their ailments. HealthCare Travel Council Of India ensures that each patient gets connected with the most experienced Andrology and Urology specialist to get the ideal and successful treatment for their problems. HealthCare Travel Council Of India is popular for providing the most convenient and cost-effective customized tourism assistance for getting medical treatments all over the world.
What are the various Obstetric and Gynecological disorders and their treatments?
Price:- From ₹ After Evaluation

An obstetric-gynecologists work entails treating vast number of medical disorders that affect a woman’s reproductive system mainly. The complete list of medical problems treated through OB-GYN expertise is extensive sub-categorized and classified into various segments.
Some of the most common obstetric and gynecological disorders and their effective treatments are:
Female Pelvic Medicine/Reconstructive Surgery
These medical disorders/injuries are mainly in the pelvic region in women. Although, there are various disorders and treatments for such disorders, the most commonly seen are:
- Pelvic organ collapse – This causes pelvic organs to lose their place and form hernias. Pelvic organs, such as uterus, apex/posterior vaginal structure, etc which can experience varying degrees of prolapse, especially due to advancing age.
- Vesicovaginal fistula (VVF) – VVF is another form of UGF (uro-genital fistula) which forms a fistulous path from the bladder to the vagina. This results in constant involuntary discharge of urine into the vault of the vagina.
General Gynecology
This segment of OB-GYN handles a large variety of medical disorders that are commonly seen affecting the reproductive system, as well as general women’s well-being.
These are some of the most commonly treated general gynecological disorders:
- Menorrhagia – Heavy menstrual periods which are not normal are treated using various methods.
- Metrorrhagia – Another menstrual condition that causes irregular menstrual periods.
- Ovarian cysts – Small abnormal growth seen developing in the walls of the ovaries, which at times can create more uncomfortable and painful complications.
Minimally Invasive Gynecology Surgery
This is one of the most advanced and effective form of surgical procedure that is used in various forms to perform the best and most efficient surgical treatment for a variety of gynecological disorders.
Some of the most advanced minimally invasive gynecological treatment techniques include:
- Cervical Loop Electrode Excision Procedure (LEEP)
- Diagnostic hysteroscopy
- Diagnostic laparoscopy
- CO2 Laser treatment
- Endometrial ablation
- Operative hysteroscopy – (to remove polyps, fibroids, uterine septa and sterilization)
- Operative laparoscopy – (to remove fallopian tubes, ovaries, ovarian cysts and for sterilization, etc)
- Vulvar vestibulectomy
Gynecological Oncology
Another important part of the OB-GYN field is the detection, diagnosis, treatment, palliative care and other services for the large variety of cancers (malignant and benign) that affect a woman’s reproductive system, such as:
- Ovarian cancer
- Vaginal cancer
- Vulva cancer
The treatments for these cancers mostly include a number of effective treatment methods, such as chemotherapy, radiotherapy or surgery. Hysterectomies may be advised by doctors in case it can easily treat non-cancerous conditions.
HealthCare Travel Council Of India has been providing effective and convenient obstetric and gynecological healthcare treatment to thousands of women across the world. HEALTHCARE TRAVEL COUNCIL OF INDIA is renowned world-wide for providing fast communication between patient and OB-GYN experts. HealthCare Travel Council Of India offers medical treatments in various popular international destinations, including India, US, UK, Thailand and Dubai according to the patient’s convenience.
What is Brain Tumor?
Price:- From ₹ After Evaluation

A brain tumor is defined as an abnormal growth of cells in the brain tissue. These are categorized into two kinds:
Benign Brain Tumors
A benign brain tumor is non-cancerous, in the sense that it is not at risk of spreading. Benign brain tumors are clearly defined and are mostly superficial on the brain. This makes it easier to remove them surgically if they are in a part of the brain which is efficiently accessible.
Malignant Brain Tumors
Malignant brain tumors are primary brain tumors which also originate in the brain and grow faster than a benign brain tumor. These are cancerous in nature that grow and spread to affect the surrounding healthy tissue as well. These are known to spread to other parts of the brain and the central nervous system as well.
Malignant brain tissues grow larger in size as well as spread more widely to affect the surrounding healthy tissue. The brain tissue gets inflamed and experiences increasing pressure due to the growing cells and the skull.
How can you identify the signs and symptoms of Brain Tumor?
The signs and symptoms of brain tumor varies according to the type, size and its location in the brain. The location of the brain tumor will mostly decide the symptoms, as small areas of the brain are designed to control varying body functions.
Some of the brain tumors may be benign and not show any noticeable signs until they are considerably larger in size and then immediately cause a series of dangerous effects on the body. At the same times, most brain tumors are slow in growth and show various signs and symptoms as they develop.
The most common problem seen in brain tumor cases is the constant headaches. These frequent and randomly occurring headaches are usually not treated with conventional medicinal treatment. However, such headaches may also be experienced due to other reasons than a brain tumor as well.
Most of the commonly seen symptoms of brain tumors are:
• Seizures
• Damaged vision
• Damaged speech
• Damaged hearing
• Balancing problem
• Walking problem
• Tingling/numbness in arm or leg
• Memory problems
• Changes in personality
• Concentration problems
• Weakness in a specific part of the body
Although these symptoms can also be caused due to a variety of other reasons, it is always advisable to seek quick medical consultation in case any of these symptoms are seen.
How are Brain Tumors diagnosed?
The physician or doctor usually begin investigation into a suspected brain tumor case by asking familiar questions, such as previous medical history, prevalence of brain tumor in the family, complete physical exam as well as a series of advanced diagnostic tests to confirm.
One of the following tests is usually performed to determine the presence of brain tumor in a person:
Imaging tests
The doctor may advise to undergo CT (computerized tomography) scan or an MRI (magnetic resonance imaging) tests to get a good look at the suspected brain tumor.
Angiogram/MRA – This involves using a minimally invasive surgical method. The procedure requires first injecting an organic dye and use advanced x-ray imaging technology to view the blood vessels in the brain and look for abnormalities in the blood supply indicating towards an anomaly.
Another method for determining the presence and the type of brain tumor is biopsy. This requires making an incision to reach the suspected tumor mass in the brain. Today, with advanced surgical technology doctors can perform this procedure on a patient using least invasive surgical methods that require a very short time and are also considerably safer. The biopsy procedure requires the doctor to remove a small portion of the abnormal tissue and analyze it in detail at a pathology laboratory.
How are Brain Tumors treated?
There are a variety of conventional and innovative treatment methods for brain tumors. The doctor will consider various factors, such as the type, size and location of the tumor as well as your overall health to decide the best-suited and most effective brain tumor treatment method.
These are the various brain tumor treatment methods:
Surgery
Surgical removal of brain tumor is one of the most common methods of brain tumor treatment. The surgeon will usually remove the entire tumor as well as a small part of the surrounding healthy tissue to prevent the risk of the cancer recurring in the future.
Surgery is usually one of the priority treatments for brain tumors, if the tumor is situated in a part of the brain which is easily accessible to a surgeon and there is no risk of damage to the surrounding healthy tissue and parts of the brain.
In case the tumor is in a considerably inaccessible part of the brain, the surgeon will then remove much of the tumor mass with surgical methods and the remaining part of the tumor is eventually destroyed with another tumor treatment technique, such as chemotherapy or radiotherapy.
Radiotherapy
Radiation therapy (or radiotherapy) is another non-invasive brain tumor treatment technique. This uses high-energy x-rays (or similar particle waves) to destroy cancerous tumor cells. This treatment method is also useful in slowing the growth as well as stopping the growth of the brain tumor completely.
Chemotherapy
This brain tumor treatment method requires using a variety of strong medicinal drugs to target and destroy the tumor cells. These drugs are designed to attack the tumor cells’ ability to divide and grow. This method is mostly used in combination with another brain tumor treatment method, such as surgery or radiotherapy, for most effective treatment.
HealthCare Travel Council Of India provides the best in effective and convenient brain tumor treatment. The company is known for providing efficient healthcare and cancer treatment in more than six popular global destinations, including US, UK and India. Effective connection for patients to expert healthcare professionals and providing comprehensive travel packages for patients to travel for a variety of medical and surgical treatments is the main function of HealthCare Travel Council Of India.